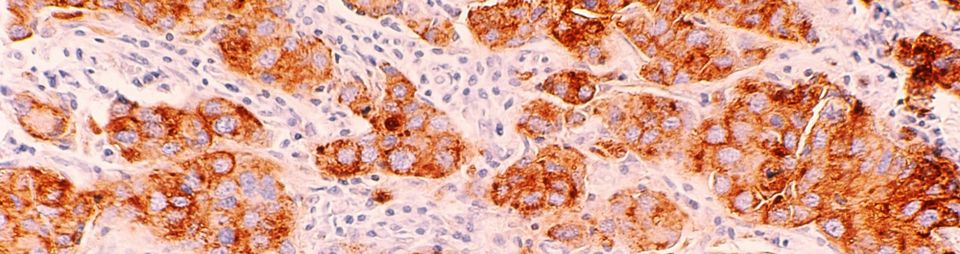
Level Up Your PD-L1 Skills!

Featured
Unlock the Secrets of Perinatal Pathology!
Invitation to Join the Next YPS Board Meeting – Have Your Say!
📢 Calling All Pathology Residents in Belgium! 📢
Announcing the Pathology Pathfinder!
Exciting News for the Young Pathologists' Section: FORPATH is Back with a Bang!
Navigating Nomensoft: An Essential Guide for Pathology Residents
"Masterclass Haematopathology for senior trainees"
Welcome to the YPS!
Education
-
Discover SpacedPath: A Fresh Approach to Learning Dermatopathology
-
Navigating Nomensoft: An Essential Guide for Pathology Residents
-
Level Up Your PD-L1 Skills!
Events
-
Conference opportunity: diagnostic histopathology of skin disease
-
Join the monthly Dermatopathology Evening next Monday (13/02/2023) from 19 to 20h on Teams!
-
Join the "Dia-Klinik" seminar next Thursday (16/02/23) at 14:30h.
-
Meet the Experts!
-
Basic Course in Molecular Pathology
News
-
Welcome to the YPS!
-
Residency position in Pathology at the University Hospital of Antwerp
-
Exciting News for the Young Pathologists' Section: FORPATH is Back with a Bang!
-
Announcing the Pathology Pathfinder!
-
📢 Calling All Pathology Residents in Belgium! 📢